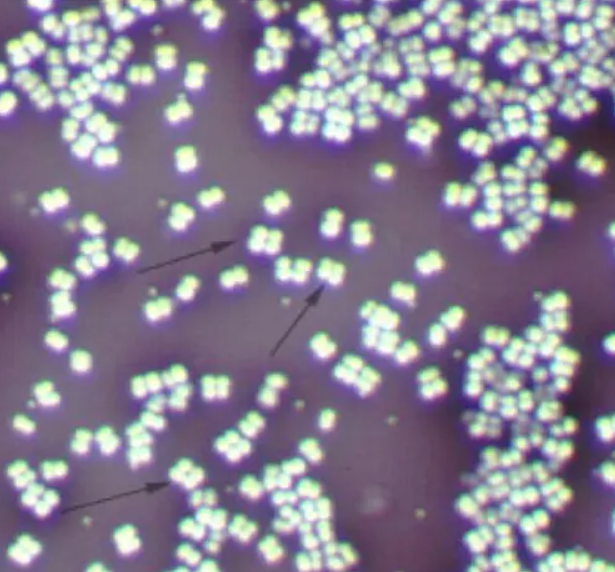

ISBN:978-7-5477-2275-6
作者:高士其
页数:151页
阅读时间:2021-12-15
推荐指数:★★★★★
很难想象这是上个世纪三十年代左右写的,
里面的个人思想和内在反省都会让人深思。
十分推荐孩童阅读的故事书,
将细菌这么微小的生物剖析的很到位。
虽然没有主线串联,
有些比较生硬和不连贯,
但是不影响孩童了解细菌的世界。

从菌儿自传说起,
描述了细菌的生活习性和自身特点。
然后进入人体后的反应,
细菌是如何与人体共生相处以及与地球和土壤的共生关系。
最后大谈特谈了细胞的新陈代谢功能,
以及对于人类生活息息相关的事物。
乳酸杆儿,是吃糖产酸。
大肠杆儿,是肠子李的淘气。
厌氧杆儿,是讨厌氧气的。
吃屎链球,是球族。
变形杆儿,是吃死肉的。
芽孢杆儿,是吃枯草烂叶。
螺旋儿,是螺旋。
酵儿和霉儿是发酵造酒。
糖发酵会变酸,
肉腐化会变臭。
人生三流:眼泪位置最高称为上流,汗全身都有称为中流,尿为下流。
植物香多臭少,动物臭多香少。
葡萄球菌:葡萄一般

链球菌:连成珠一样,有长有短。

双球菌:豆子,栗子,花生成对出现。

四联球菌:四个做成一处
八叠球菌:八个叠成的立方体。

1.【水】粪是毒菌的大本营。
2.【人】人体中咽喉病菌很多。
3.【食】食物里病毒也很多。
4.【虫】虫子携带病毒(苍蝇、虱子等)
5.【兽】兽携带的病毒(狂犬病、鼠疫等)
6.【土】泥土里面也有大量病毒(马粪溶解到泥土、虱子等)
7.【皮】皮肤病感染。
热大半都是由摩擦而发生的,动物身上的热气,也是由血液和血管之间的摩擦而产生的。


























 被折叠的 条评论
为什么被折叠?
被折叠的 条评论
为什么被折叠?










